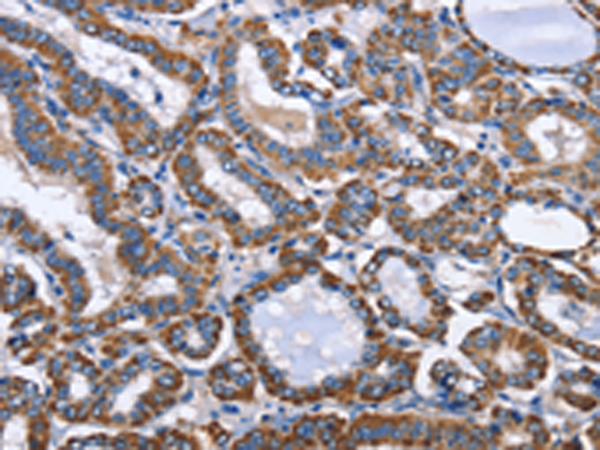
一抗

Background:
INTS10 is a subunit of the Integrator complex, which associates with the C-terminal domain of RNA polymerase II large subunit and mediates 3-prime end processing of small nuclear RNAs U1. INTS10 (integrator complex subunit 10) is also known as INT10 and is a 710 amino acid protein that is localized to the nucleus. INTS10 is a component of the integrator complex and, as such, is thought to aid in the regulation of 3’-end processing of spliceosomal U1 and U2 snRNAs.
Applications:
ELISA, WB, IHC
Name of antibody:
INTS10
Immunogen:
Fusion protein of human INTS10
Full name:
integrator complex subunit 10
Synonyms:
INT10; C8orf35
SwissProt:
Q9NVR2
ELISA Recommended dilution:
1000-5000
IHC positive control:
Human thyroid cancer and human cervical cancer
IHC Recommend dilution:
50-200
WB Predicted band size:
82 kDa
WB Positive control:
Hela and hepG2 cells
WB Recommended dilution:
200-1000
技術(shù)規(guī)格


 購(gòu)物車
購(gòu)物車 幫助
幫助
 021-54845833/15800441009
021-54845833/15800441009